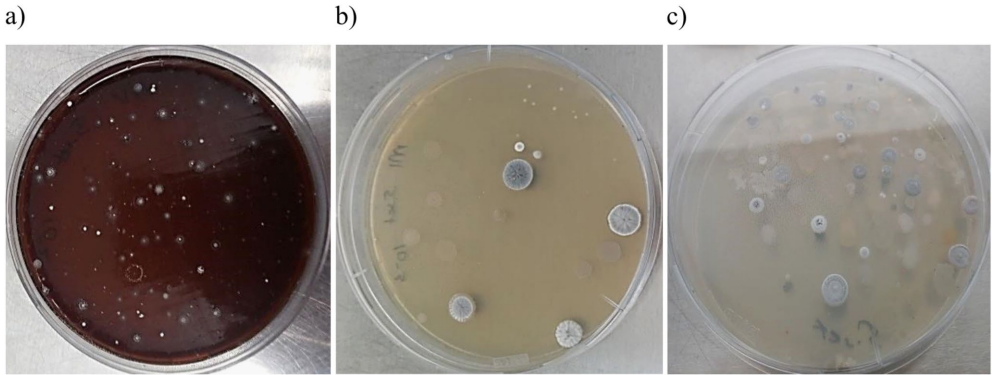

-

…ķőÔÕ®ĻŔőĘ
Ň„ń„◊•◊°…ķ√ŁŅ∆ľľ
ŐÝ∂ĮĶń¬Ų≤ę
Ņ®ņ≠Ņ‚ń∑…≥ńģ£ļĺŖ”–Ō‘÷Ý…ķőÔļŌ≥…«ĪѶĶńŅ…Ňŗ—Ý–¬–ÕŌ°”–∑ŇŌŖĺķ∂ņŐōņī‘ī
°ĺ◊÷ŐŚ£ļ īů ÷– –° °Ņ Īľš£ļ2025ńÍ06‘¬25»’ ņī‘ī£ļWorld Journal of Microbiology and Biotechnology 4
Īŗľ≠Õ∆ľŲ£ļ
°°°°Īĺ—–ĺŅ’Ž∂‘∂ŗ÷ōńÕ“©≤°‘≠ŐŚ–¬–ÕŅĻ…ķňōļÕ÷≤őÔ…ķ≥§īŔĹÝľŃĶń∆»«––Ť«ů£¨Ĺ“ ĺŃňŅ®ņ≠Ņ‚ń∑…≥ńģ◊ųő™∑ŇŌŖĺķ◊ ‘īĪ¶Ņ‚Ķń∂ņŐōľŘ÷Ķ°£—–ĺŅ»ň‘ĪÕ®Ļż16÷÷—°‘Ů–‘Ňŗ—ÝĽýī”6łŲ≤…—ýĶ„∑÷ņŽ459÷Í∑ŇŌŖĺķ£¨ĹŠļŌ16S rRNAĽý“Ú≤‚–ÚļÕ»ęĽý“Ú◊ťÕŕĺÚľľ ű£¨∑ĘŌ÷17łŲ ŰĶń∑ŇŌŖĺķ£®įŁņ®Actinocorallia°ĘJiangellaĶ»Ō°”– Ű£©ļ¨”–Īŗ¬Ž–¬–Õīőľ∂īķ–Ľ≤ķőÔ£®ŐōĪū «ŅĻ…ķňō£©Ķń…ķőÔļŌ≥…Ľý“Úīō£®BGCs£©°£ł√—–ĺŅő™Ņ™∑Ę–¬–Õ…ķőÔĽÓ–‘őÔ÷ ŐŠĻ©ŃňłŖ÷ ŃŅĺķ÷÷Ņ‚£¨¬Řőń∑ĘĪŪ”ŕ°∂World Journal of Microbiology and Biotechnology°∑°£
‘ŕŅĻ…ķňōńÕ“©ő£Ľķ»’“ś—ŌĺĢĶńĪ≥ĺįŌ¬£¨—į’“–¬–ÕőĘ…ķőÔ◊ ‘ī≥…ő™»ę«ÚŅ∆—–»»Ķ„°£īęÕ≥∑ŇŌŖĺķņī‘ī£®»ÁÕŃ»ņ≥£ĻśĽ∑ĺ≥£©ĶńŅ™∑Ę“—«ųĪ•ļÕ£¨∂Ýľę∂ňĽ∑ĺ≥őĘ…ķőÔ“Ú∆š∂ņŐōĶń…ķīś≤Ŗ¬‘ļÕīķ–ĽÕĺĺ∂£¨’ż≥…ő™"īőľ∂īķ–Ľ≤ķőÔĹūŅů"°£÷–—«Ņ®ņ≠Ņ‚ń∑…≥ńģ◊ųő™»ę«Ú◊Ół…ļĶ—◊»»Ķń…ķŐ¨ŌĶÕ≥÷ģ“Ľ£®ŌńľĺĶōĪŪő¬∂»≥¨80°„C£©£¨∆šőĘ…ķőÔ◊ ‘ī≥§∆ŕőīĪĽŌĶÕ≥—–ĺŅ°£
ÕŃ∂ķ∆šŅ∆—ßľ“Hayrettin SayginÕŇ∂”Ń™ļŌ”ĘĻķҶŅ®ňĻ∂Żīů—ßMichael GoodfellowĹŐ ŕ£¨≤…”√∂ŗ—ßŅ∆ĹĽ≤ś≤Ŗ¬‘∂‘ł√…≥ńģ∑ŇŌŖĺķ◊ ‘īĹÝ––…Ó∂»ÕŕĺÚ°£—–ĺŅÕŇ∂”ī”6łŲ‘≠ ľ≤…—ýĶ„ĽŮ»°ÕŃ»ņ—ýĪĺ£¨Õ®ĻżpH÷Ķ£®8.25-8.71£©°ĘĶÁĶľ¬ £®0.12-0.75 dS/m£©Ķ»ņŪĽĮ∑÷őŲ»∑»Ō∆šľę∂ňŐō–‘°£ Ļ”√16÷÷—°‘Ů–‘Ňŗ—ÝĽý£®»ÁŐŪľ”–¬…ķ√ĻňōĶńļ£—ů«Ū÷¨°Ęļ¨łĮ÷≥ňŠĶńő¨…ķňō«Ū÷¨Ķ»£©∑÷ņŽ≥Ų459÷Í∑ŇŌŖĺķ£¨Õ®Ļż—’…ę∑÷◊ťļÕ16S rRNAĽý“Ú≤‚–Ú£®“żőÔ27F/1525R£©…ł—°270÷ÍīķĪŪĺķ÷Í°£∂‘32÷ÍŌĶÕ≥∑Ę”ż∂ņŐōĶńĺķ÷ÍĹÝ––»ęĽý“Ú◊ť≤‚–Ú£®Illumina HiSeq 2500∆ĹŐ®£©£¨ņŻ”√antiSMASH v7.0‘§≤‚…ķőÔļŌ≥…Ľý“Úīō£®BGCs£©£¨≤ĘÕ®ĻżTYGS∆ĹŐ®ĻĻĹ®ŌĶÕ≥Ľý“Ú◊ť ų°£
—–ĺŅ∑Ĺ∑®ŃŃĶ„
1£©∂ŗő¨∂»—°‘Ů–‘Ňŗ—Ý≤Ŗ¬‘ł≤ł«Ļ„∆◊∑ŇŌŖĺķņŗ»ļ
2£©’ŻļŌ–őŐ¨—ߣ®śŖ◊”—’…ę∑÷◊ť£©”Ž∑÷◊”∑÷ņŗ—ߣ®16S rRNAĽý“ÚŌŗň∆∂»<99.3%ĹÁ∂®–¬÷÷£©
3£©»ęĽý“Ú◊ťÕŕĺÚ”ŽĪŪ–Õ…ł—°£®’Ž∂‘8÷÷≤°‘≠ĺķĶń“÷ĺķ Ķ—ť£©ŌŗĹŠļŌ
ĻōľŁ∑ĘŌ÷
ÕĽ∆∆–‘ĹŠ¬Ř
1£© ◊īőŌĶÕ≥÷§ ĶŅ®ņ≠Ņ‚ń∑…≥ńģ «∑ŇŌŖĺķ∂ŗ—ý–‘»»Ķ„£¨∆šĺķ÷ÍĺŖ”–"ňę÷ōŐžł≥"°™°™ľ»ń‹≤ķ…ķ–¬–ÕŅĻ…ķňō£®»Áņŗň∆vicenistatinĶńīůĽ∑ńŕű•£©£¨”÷ļ¨÷≤őÔīŔ…ķĽý“Úīō
2£©Ĺ®ŃĘįŁļ¨∂ŗłŲ–¬∑÷ņŗĶ•‘™£®»ÁJiangella ureilytica KC603T£©ĶńłŖ÷ ŃŅĺķ÷÷Ņ‚£¨ő™"ī”∑÷ņŗ—ßĶĹ“©őÔ∑ĘŌ÷"ŐŠĻ©∑∂ņż
3£©Ĺ“ ĺ…≥ńģ∑ŇŌŖĺķĽý“Ú◊ť÷–īś‘ŕ”Ž“—÷™ŅĻ…ķňō£®»Áļž√Ļňō°ĘňńĽ∑ňō£©ĹŠĻĻŌŗň∆ĶęĻ¶ń‹Ņ…ń‹īī–¬Ķń…ķőÔļŌ≥…Õĺĺ∂
ł√—–ĺŅő™Ņ™∑ĘŅĻńÕ“©ĺķ“©őÔļÕ…ķըҩ“Ķ÷∆ľŃŐŠĻ©Ńň»ę–¬◊ ‘ī£¨∆š"ľę∂ňĽ∑ĺ≥-őĘ…ķőÔ∑÷ņŗ-Ľý“Ú◊ťÕŕĺÚ"»żőĽ“ĽŐŚ—–ĺŅ∑∂ Ĺ∂‘őĘ…ķőÔ◊ ‘īŅ™∑ĘĺŖ”–∆’ –‘÷łĶľ“‚“Ś°£¬Řőń÷–∑ĘŌ÷Ķń∂ŗłŲŌ°”– Űĺķ÷Í£®»ÁĹŲ∑÷ņŽĶĹ1÷ÍĶńSpongiactinospora£©ŐŠ ĺ…≥ńģ…ķŐ¨ŌĶÕ≥»‘īś‘ŕĺřīůŐĹňųŅ’ľš°£
 …ķőÔÕ®őĘ–ŇĻę÷ŕļŇ
…ķőÔÕ®őĘ–ŇĻę÷ŕļŇ
÷™√Ż∆ů“Ķ’–∆ł
ĹŮ»’∂ĮŐ¨ | »ň≤Ň –≥° | –¬ľľ ű◊®ņł | ÷–ĻķŅ∆—ß»ň | ‘∆’ĻŐ® | BioHot | ‘∆Ĺ≤Ő√÷Ī≤• | ĽŠ’Ļ÷––ń | ŐōľŘ◊®ņł | ľľ űŅž—∂ | √‚∑— ‘”√
įś»®ňý”– …ķőÔÕ®
Copyright© eBiotrade.com, All Rights Reserved
Ń™ŌĶ–ŇŌš£ļ
‘ŃICPĪł09063491ļŇ